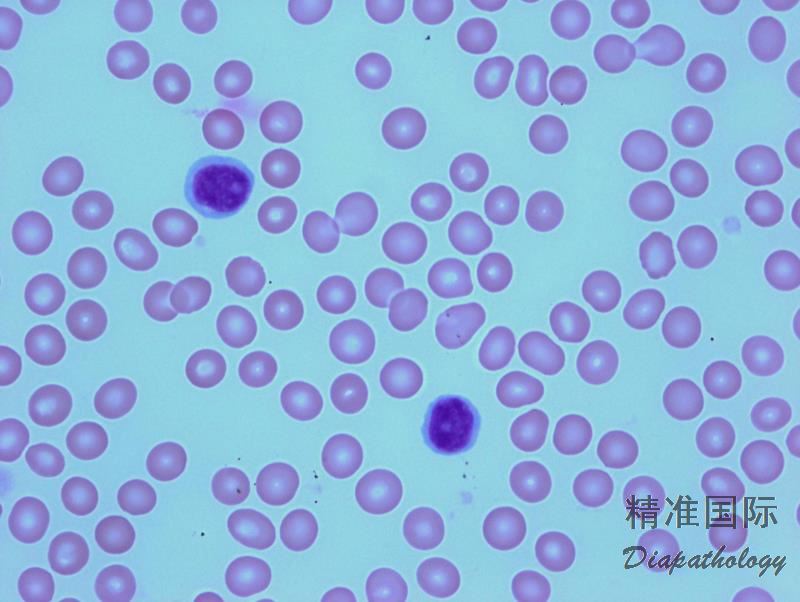
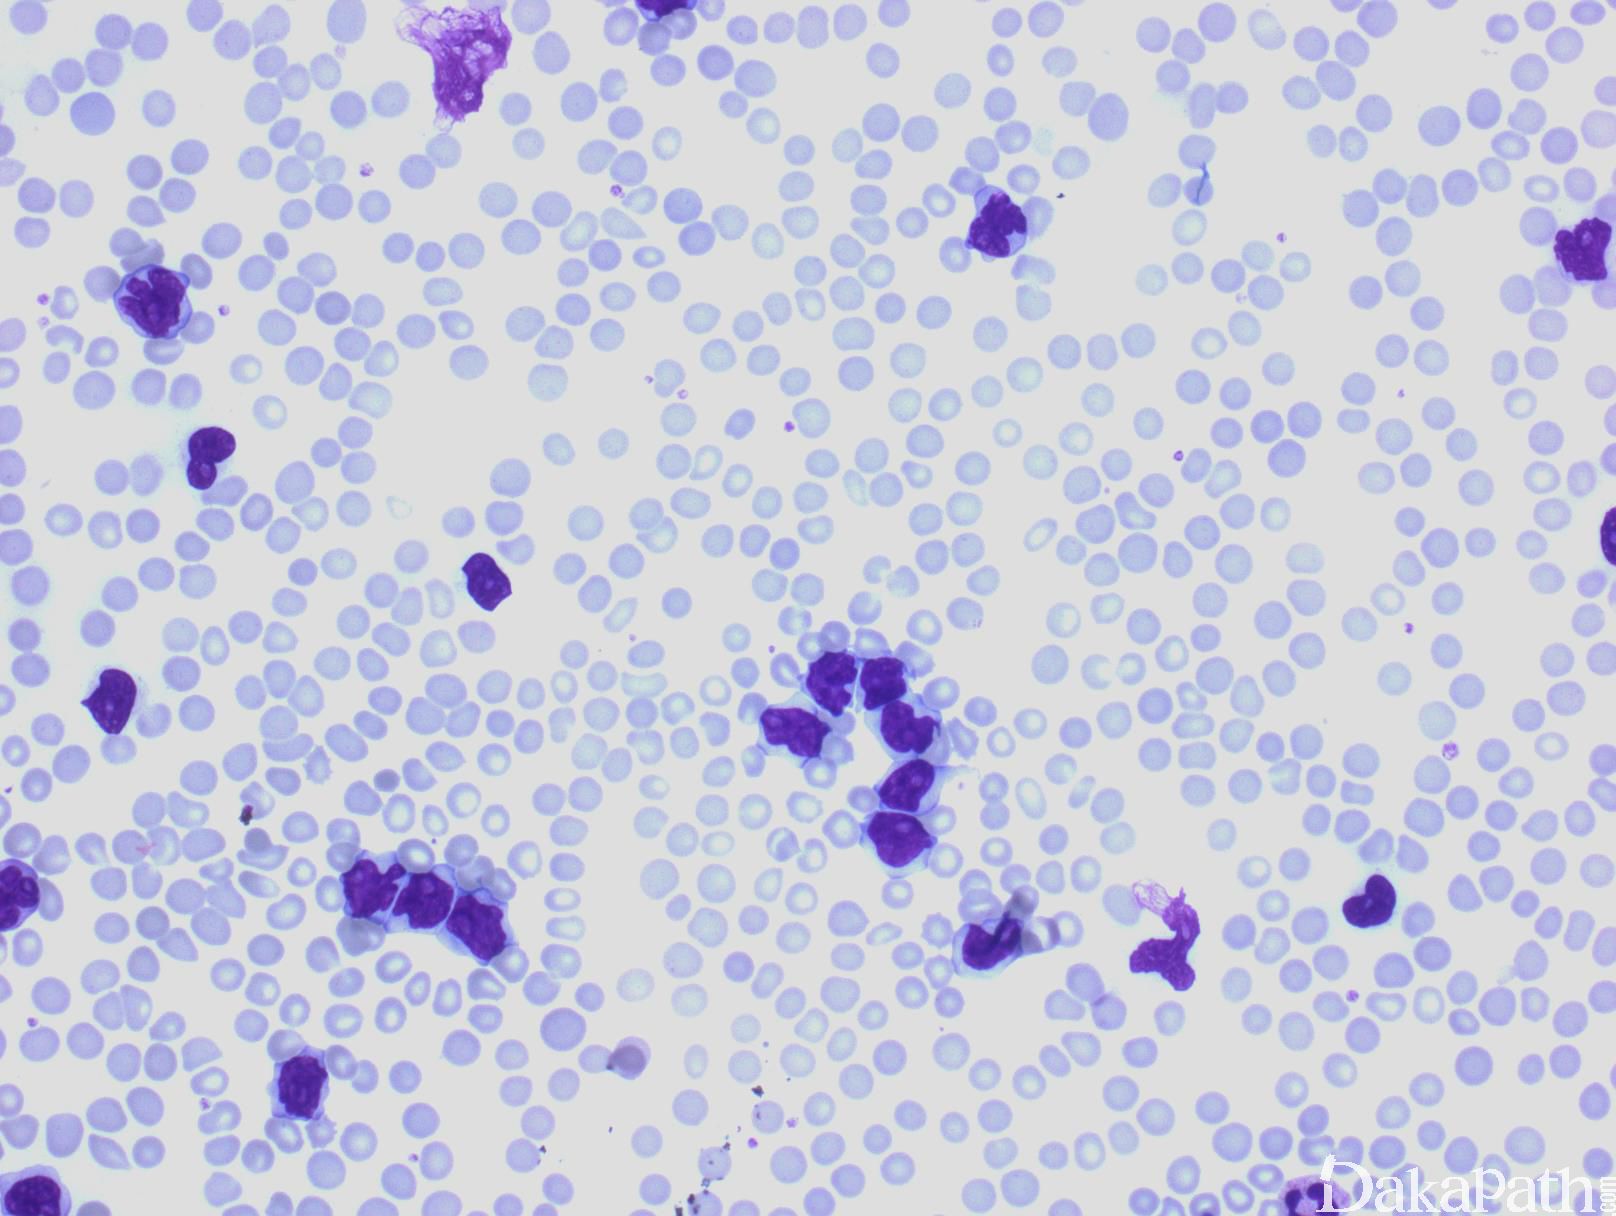
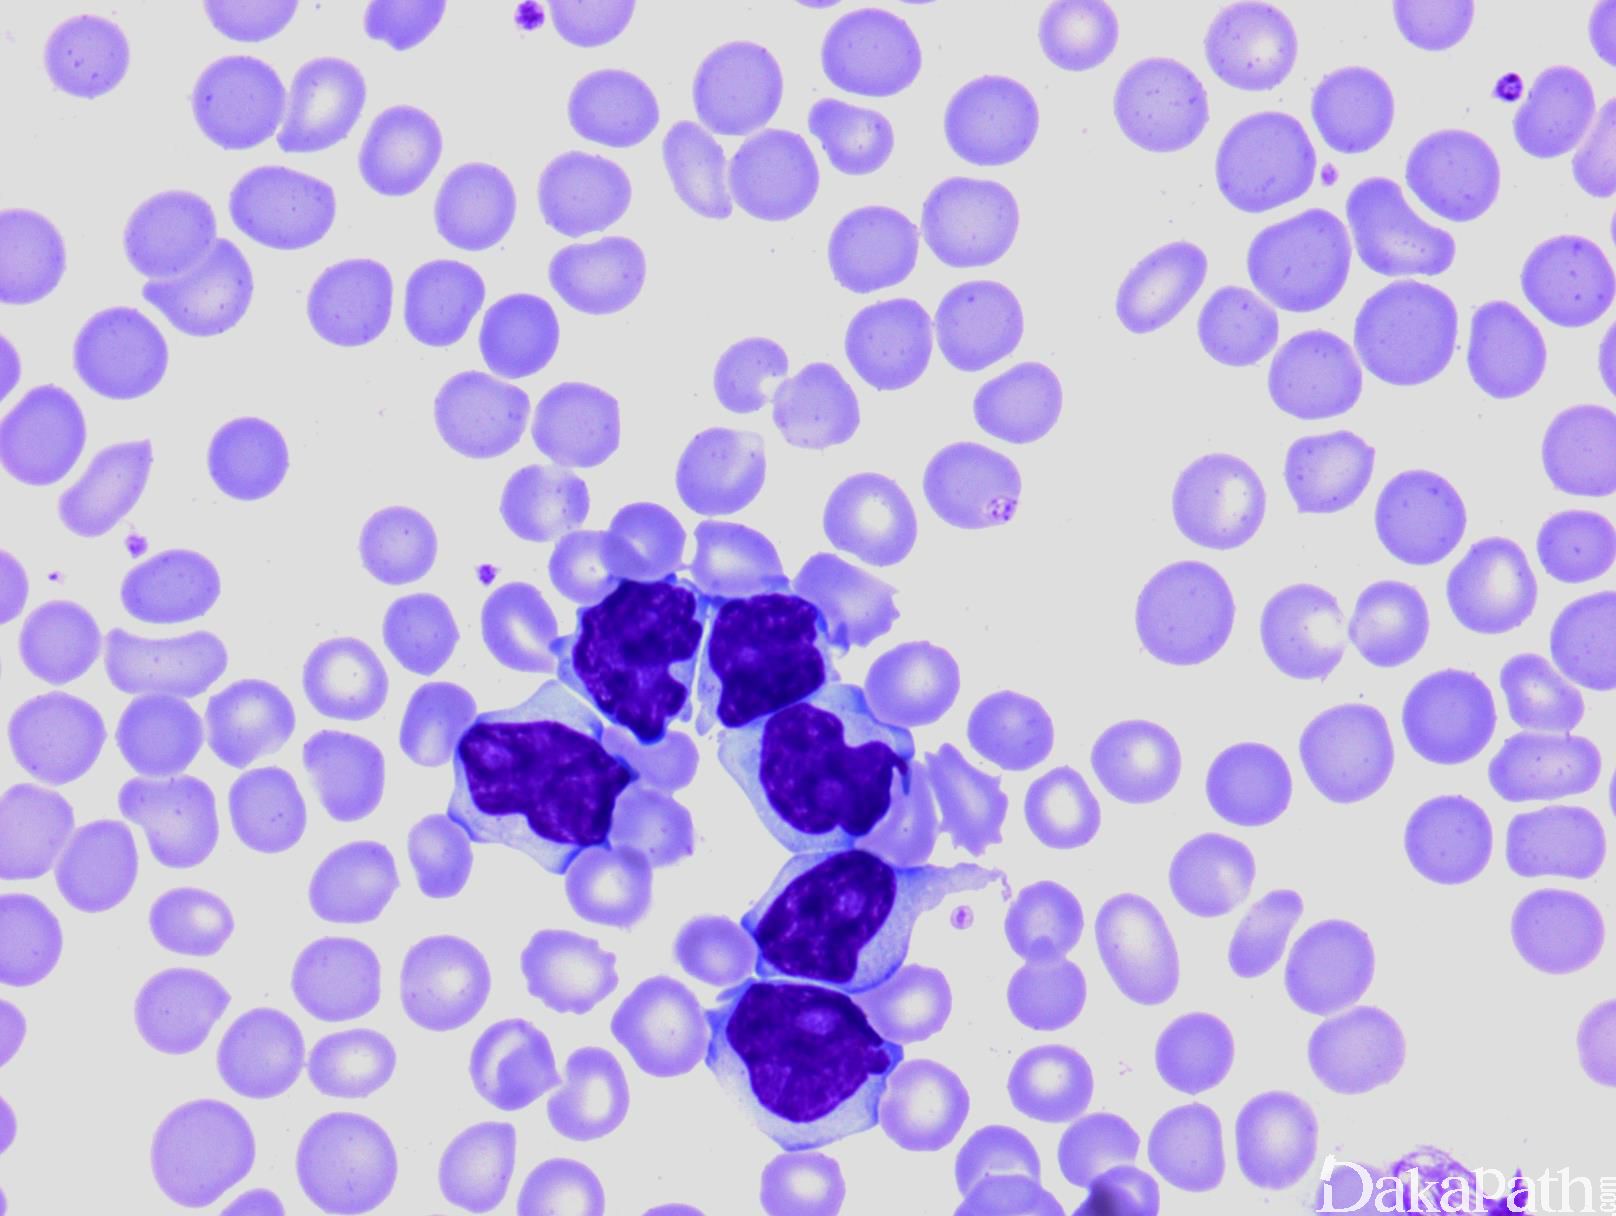

T 细胞幼淋巴细胞白血病
T-Cell Prolymphocytic Leukemia, T-PLL
概述:
T-PLL 是一种侵袭性 T 细胞白血病,特点是小到中等大小的成熟(胸腺后表型)淋巴细胞增生,累及血液、骨髓、淋巴结、肝脾脏和皮肤。
诊断要点:
主要见于中老年(30 岁以下非常少见)。常见累及部位包括血液、骨髓、淋巴结、肝、脾和皮肤。表现为全身症状、肝脾肿大、淋巴结肿大、皮肤病变。
全血细胞计数淋巴细胞显著升高,常>100 x 109/L,贫血、血小板减少。
形态学诊断主要根据外周血涂片。淋巴细胞中等大小,核圆、椭圆或不规则形(5%病例呈现脑回样核),染色质中度致密,有明显的中位核仁,胞质丰富、嗜碱性,无颗粒,常有胞质泡状突起。有的病例(25%)表现为小型淋巴细胞增生(小细胞亚型),核仁不明显。
骨髓常表现为弥漫侵润;皮肤为血管周围侵润或真皮弥漫侵润,但不累及表皮;脾脏主要侵犯红髓;淋巴结多侵润副皮质区。
免疫表型:CD3+、CD2+、CD5+、CD7+、TCL-1+、CD26+、CD52+,60%病例表达 CD4+/CD8-,25%病例特征性表达 CD4+/CD8+,15%病例表达 CD4-/CD8+,也有报道 30%病例表达 S100。CD56-,CD57-,CD16-,TIA1-,粒酶 B-,TdT-,CD34-,CD1a-。
EBER-
α-醋酸萘酯酶染色:高尔基区点状阳性
血清 HTLV-1 阴性。
inv(14)(q11;q32.1)(80%),t(14;14)(q11;q32.1)(10%),70-80%患者有 8 号染色体异常;有的获得 MYC 或缺失 12p13. 22q、11q23;也有报道 JAK3 或 JAK1 突变,也罕见 EZH2 或 BCOR 突变。TCR 基因克隆性重排。

免疫组织化学染色:
CD3+、CD2+、CD5+、CD7+、TCL-1+、CD26+,60%病例 CD4+/CD8-,25%病例特征性 CD4+/CD8+,15%病例 CD4-/CD8+。CD56-,CD57-,CD16-,TIA1-,粒酶 B-,TdT-,CD34-,CD1a-。EBER-。
分子标记:
inv(14)(q11;q32.1)(80%),t(14;14)(q11;q32.1) (10%);TCR 基因克隆性重排
鉴别诊断:
- 成人 T 细胞白血病 / 淋巴瘤 (ATLL) :患者携带 HTLV-1,血清检查阳性。淋巴细胞异形分叶(花细胞),表达 CD3. CD25,但 通常不表达 CD7。常有高血钙症。
- Sezary 综合症 :常有蕈样肉芽肿病史,外周淋巴细胞升高程度相对较低,呈现脑回样核,免疫表型通常是 CD3+、CD4+、CD7-、CD26-。
- T 细胞大颗粒淋巴细胞白血病 (T-LGLL): 增生的淋巴细胞含胞浆颗粒,常伴粒细胞减少、贫血和自身免疫病(类风湿关节炎)。细胞免疫表型通常是 CD3+、CD8+、CD4-。临床进展缓慢惰性。
- 肝脾 T 细胞淋巴瘤 (HSTCL):临床表现为显著肝脾肿大,一般无淋巴结肿大。外周血循环瘤细胞相对较少,中等大小,可见稀疏胞浆颗粒。多数病例为 TCRγδ 表型:CD3+、CD56+、CD4-、CD8-/+、CD5-、TCRδ1+、TCRαβ-。
- T 淋巴母细胞白血病/淋巴瘤 (T-ALL):循环瘤细胞多少不等,有的病例极度升高。常伴有纵隔肿块和弥漫侵犯骨髓。细胞呈不成熟母细胞形态,表达 CD3(胞浆)、CD34. TDT、CD1a。
预后:
临床表现为侵袭性。中位存活期 1-2 年,少数 2-3 年。
